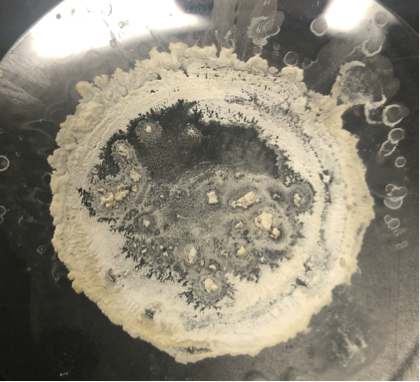
dried extracted caffeine

The Extraction of Caffeine from Tea—with Several Important Outcomes

Good day, Gentle Readers:
After a recent study of Intermolecular Forces, my AP Chemistry students experienced the joy of performing a microscale extraction of caffeine from tea.
Each pair of students was given about 10 mL of concentrated, basified1 tea. Using a ca 15 mL plastic centrifuge tube with a screw-on lid as a “separatory funnel”, they performed three successive two-mL extractions using dichloromethane. After each extraction, a disposable pipet was used to suction the more-dense caffeine-containing CH2Cl2. At the end of the activity, the students’ dichloromethane extractions were pooled; the solvent was distilled2 after class for re-use.
The following day students were shown their dried caffeine3.
I gotta’ say, for a bunch of near-rookies, their extracted caffeine looks pretty good—almost pure white.
A short period of self-congratulation ensued.
Then I asked for questions. After some prompting, a student asked the most important question:
“How do we know it’s caffeine?”
My answer was a rather disappointing, “We don’t”, followed by a discussion of how to purify the sample4, and the use of melting point as an identifier, along with other physical and chemical tests.
Now, more than ever, claims—of anything—must be substantiated with empirical evidence from well designed, proper experiments, properly carried out and properly interpreted.
After this oft-repeated epistle, I demonstrate a distillation. For maximum effect, I distill nail polish remover5. Students see the colored nail polish remover boiling in the ‘stil pot, and the drip, drip, drip of clear, colourless acetone (bp 56oC) or ethyl acetate (bp 77oC) into the receiving vessel.
Students have reported this observation to be “very cool”.
During the distillation, we discuss:
- the need for boiling stones or a magnetic stirrer
- that the lowest boiling component of the mixture will distill first
- how a condenser works
- that in our experiment, CH2Cl2 distilled at ca 40oC, leaving the caffeine behind
- as a compound is distilling, its boiling point is shown on the thermometer at the ‘stil head
- the temperature at the ‘stil head is NOT the boiling point of the solution or mixture in the ‘stil pot—we typically do not measure—or care about—the boiling point of the solution or mixture that is undergoing distillation
- how intermolecular forces are at play
May peace be with you.
- basified with Na2CO3, to ensure caffeine in its free-base form
- CH2Cl2 boiling point is 39.6oC (https://en.wikipedia.org/wiki/Dichloromethane)
- boiling stones are visible near the center
- by sublimation at low pressure—to be studied in an upcoming lesson on phase diagrams
- acetone or ethyl acetate-based nail polish removers can be used
- I have a separate condenser on hand to demonstrate. I ask: “For what are coat hangers used? What do lawn mowers do? What’s the point of a condenser?”
Materials
Per pair of students
- 10 mL of cold, concentrated tea(aq), basified with 11g of Na2CO3∙HOH per 15 g of tea leaves
- 6 mL CH2Cl2
- 2 – 50 mL beakers
- ca. 15 mL plastic centrifuge tube (i.e. conical bottom) with screw top lid or tightly fitting rubber stopper. A test tube with stopper may be substituted if no conical tubes are available
- disposable glass Pasteur pipet with removable rubber pipet bulb or plastic Beral pipet
Background
Covalent (or molecular) compounds can be polar or non-polar, although there are various degrees of molecular polarity. Polar compounds have an overall dipole, owing to polar bonds whose dipole vectors do not cancel, or to the presence of lone pair(s) of electrons on the central atom. (Water-soluble ionic compounds are considered to be polar in the extreme—ionic, that is.) By contrast, non-polar compounds have no net dipole. This can arise because
- all of the bonds in the molecule are non-polar, or
- any polar bonds (ie dipole vectors) cancel, resulting in an overall dipole of zero, or close to it. As stated above, non-polar-looking compounds with one or more lone pairs of electrons on the central atom may be polar. Treat these on an individual basis.
In this experiment students will extract caffeine from tea. Caffeine is a somewhat non-polar compound with significant solubility in hot water and in dichloromethane, CH2Cl2 (aka methylene chloride).
Procedure
- Add ca 2 mL of CH2Cl2 to the plastic centrifuge tube containing ca 10 mL of tea—aqueous caffeine. Put the lid securely on the centrifuge tube and invert it about 20 times to allow the CH2Cl2 to thoroughly come in contact with the tea. Do not shake vigorously; the organic and aqueous layers will form an emulsion that will not separate quickly or cleanly.
- When the CH2Cl2 layer has separated, carefully remove it from the centrifuge tube with a glass Pasteur pipet as demonstrated. That is, squeeze the pipet bulb and insert it to the bottom of the centrifuge tube. Carefully release the bulb to draw the caffeine-containing CH2Cl2 solution into the pipet. It is okay to draw some tea along with the dichloromethane solution. Put the caffeine-containing CH2Cl2 solution into a small beaker.
- Extract the remaining caffeine with two more 2 mL portions of CH2Cl2. Add the caffeine-containing CH2Cl2 to the flask.
- Add your 6 mL of caffeine-containing dichloromethane to the labelled flask indicated by the teacher. Dispose of your “decaffeinated” tea in the chemical waste beaker provided.
The teacher will pool the caffeine-containing CH2Cl2 and will subsequently distill—and recover—the CH2Cl2. You will see the relatively pure caffeine next class.
Safety Notes
Wear safety goggles and nitrile/latex gloves. Dispose of the “decaffeinated” tea in the chemical waste beaker provided. Perform the extractions in a fume hood or in a well ventilated space.
Questions
Pre and Post Lab questions are included in the student document that can be found in the Supporting Information when the reader is logged into their ChemEd X account.
Concepts
Time Required
Preparation
Teacher prep time involves making concentrated tea (4 tea bags per 100 mL water; basify by adding Na2CO3 to pH 11-12 with test paper) and allowing the tea to cool.
After the extraction: In a separatory funnel, separate any tea from the students’ caffeine-bearing CH2Cl2. Add anhydrous MgSO4 to dry this solution before distilling the CH2Cl2 for re-use.
Teacher time is also required to set up and carry out the distillation to remove CH2Cl2, and to ready the distillation of nail polish remover demonstration.
See the Periodic Videos crew demonstrate the Extraction of Caffeine from Coffee.
Attribution
N/A